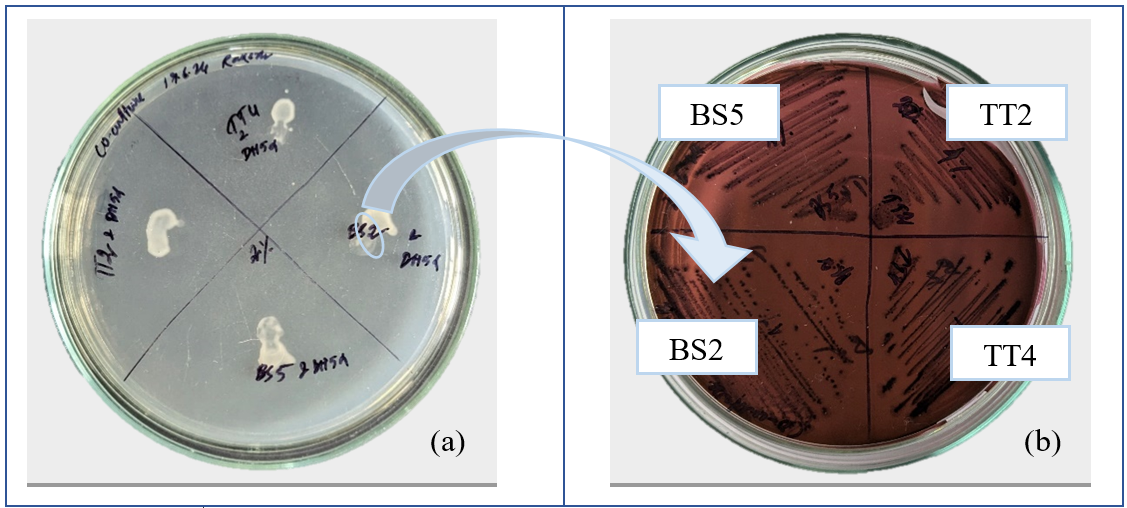

Department of Biotechnology and Bioinformatics, North-Eastern Hill University, Shillong-793022, Meghalaya, India
*Corresponding author: S. R. Joshi; *Email: srjoshi2006@yahoo.co.in
Received: 19 Sep 2024, Revised and Accepted: 08 Nov 2024
ABSTRACT
Objective: The present study aimed to isolate, identify, and analyze the probiotic properties and β-lactam sensitivity in the Lactic Acid Bacteria (LAB) prevalent in Tungtap and Lung-seij, common traditionally fermented ethnic products throughout Meghalaya.
Methods: Bacterial pure colonies were identified using conventional biochemical tests and 16S rRNA Sanger sequencing. Slightly modified standard protocols were followed for the assessment of different probiotic properties.
Results: The selected LAB isolates were found Gram-positive, catalase, and oxidase-negative and exhibited resistance to most of the β-lactam antibiotics used in this study. No significant antibacterial activity was shown against tested strains. However, they showed strong bile salt and acid tolerance, as well as high auto aggregation and moderate hydrophobicity properties, which represent their probiotics properties. Extracellular Polymeric Substances (EPS) yield was highest for the TT2 isolate, while TT10 showed maximal siderophore production. Biofilm formation varied, with BS2 and BS5 showing strong adherence. Sequencing results confirm that the majority of the isolates belonged to the Lactiplantibacillus and Ligilactibacillus genera. Moreover, further genetic analysis confirmed the presence of β-lactamase genes in the selected isolates.
Conclusion: The presence of these genes suggests that the isolates may become reservoirs for Antimicrobial Resistance Genes (ARG) in traditional fermented foods. Further study is required to establish whether the isolates are transmitting their antimicrobial resistance genes during co-culture under different stress conditions and transportation.
Keywords: Tungtap, Lungsiej, Ethnic products, Lactic acid bacteria, Antibiotic resistance, β-lactam resistance
© 2024 The Authors. Published by Innovare Academic Sciences Pvt Ltd. This is an open access article under the CC BY license (https://creativecommons.org/licenses/by/4.0/)
DOI: https://dx.doi.org/10.22159/ijpps.2024v16i12.52716 Journal homepage: https://innovareacademics.in/journals/index.php/ijpps
‘Fermentation’ originated from the Latin word ‘fervere’, which means ‘to boil.’ It describes the process where yeast acts upon fruit or malted grain extracts, particularly in producing alcoholic beverages [1]. It is an ancient and cost-effective method of food preparation that utilizes microorganisms’ growth and metabolic activities to preserve foods. Fermentation is widely practiced at the household level in rural communities; it yields a variety of traditional foods and beverages. This inexpensive process requires minimal energy and service as the primary method of food, typically retaining pleasant flavor, aroma, and texture while boasting enhanced nutritive values and extended shelf life under ambient conditions. Ethnic fermented foods are crafted by indigenous communities using their traditional knowledge of food fermentation. They use locally available plant-or animal-based raw materials, employing natural or spontaneous fermentation, or add starter cultures containing functional microorganisms. These practices transform substrates into edible products that align with cultural and social norms through biochemical and organoleptic modifications, ensuring consumer acceptance [2]. Majorly, Lactic Acid Bacteria (LAB) are found in fermented foods and beverages. Key genera of LAB, including Lactobacillus, Alkalibacterium, Carnobacterium, Enterococcus, Leuconostoc, Pediococcus, Streptococcus, and Weissella have been identified and isolated [1]. These isolates are widely known for their health benefits attributes and have been implicated for health benefits while being Generally Regarded As Safe (GRAS) nature [3]. With the increase in the use of antimicrobial drugs and their constant exposure to these drugs, the GRAS probiotic microbes are growing in the chemical-rich environment, thus providing the possibility of acquired genetic recombination, which may even include the Antimicrobial Resistance Gene (ARG).
Understanding the prevalence and transferability of antibiotic-resistant genes in bacteria associated with ethnically fermented food products is essential for mitigating the potential risks associated with their consumption [4]. Considering the ethnic practices of preparing and consuming traditionally fermented foods, the present work was proposed to evaluate lactic acid bacteria’s prevalence in these products available in Meghalaya and assess their probiotic properties as well as the susceptibility of the isolated LAB to β-lactam antibiotics.
Samples of fermented products
Fermented fish (Tungtap) and fermented bamboo shoots (Lung-seij) were collected from the local market of Shillong, Meghalaya. The pathogenic strains of Staphylococcus aureus (M96), Bacillus subtilis (M441), Escherichia coli (M730), and Klebsiella pneumoniae (M109) were purchased and subcultured from Microbial Type Culture Collection and Gene Bank, Chandigarh, India.
Isolation of lactic acid bacteria
De-Man, Rogosa, and Sharpe (MRS) is a specifically selective medium used for the isolation of lactic acid bacteria. 100 µl of previously serially diluted samples were taken from each tube, spread over separate MRS agar plates, and appropriately marked according to their dilution. The plates were kept in an anaerobic glass jar with an AnaeroGas Pack (HiMedia®, India). AnaeroGas Pack is a disposable oxygen-absorbing and carbon dioxide-generating agent. A pH tablet is generally used for conformation. Then, the jar was kept in an incubator at 37 °C for 48-72 h.
After proper growth, different single colonies were picked up using a sterile loop and streaked on MRS agar plates from the spread plate to isolate the pure colony. Streaked plates were kept in an incubator at 37 °C for 24 h. The growing colonies on plates were counted and noted for Colony-Forming Units (CFU) calculation. Single colonies were chosen based on their morphological appearance, color, shape, elevation, and margin. Further experiments were done based on the primary selection. The number of bacteria in the samples was expressed as CFU/ml.
Pure culture development and stock maintenance
After 24 h of incubation, colonies were found in the previously spread plate on MRS agar media. Particular dilution plates were chosen where the colonies were countable between 30-300. From those plates, distinct single colonies were picked up using a flame-sterilized inoculation loop based on their appearance and streaked over different MRS agar plates. Plates were marked accordingly. Then, the plates were kept in an incubator at 37 °C for 24 h in inverted conditions.
From the streaked plate, single colonies were picked up and further grown in MRS broth medium. And spread in MRS-slant tubes for short-term preservation. And 50% glycerol stock was made for each isolate by adding 1 ml of sterile glycerol and 1 ml of overnight-grown fresh broth culture. Cryo vials were labeled properly and kept in a refrigerator at -80 °C for long-term preservation.
Differential staining and biochemical tests
Gram staining is a differential staining technique used to differentiate between Gram-positive and Gram-negative bacteria based on their cell wall composition. A loopful overnight-grown fresh culture was smeared on a grease-free slide and heat-fixed by gently passing by flame for a few seconds. The smear was then flooded with crystal violet, the primary stain, for 1 min. Gram’s iodine was added for 1 min as a mordant. Decolorizer (95%) was added to it and then excess decolorizer was washed with water. Counter-stain safranin was added for 1 min and then washed with water. The slide was left at room temperature for air drying. After air drying, the slides were observed under a light microscope at 400x and 1000x oil immersion. For biochemical studies, mainly catalase and oxidase tests were done.
Antimicrobial susceptibility testing (AST)
The Clinical and Laboratory Standards Institute (CLSI, 2020) criteria were followed for assessing the antibiotic susceptibility of the isolates. Muller-Hinton Agar (MHA) media was used for determining antimicrobial susceptibility. After McFarland standardization, 100 µl of overnight-grown bacterial culture was spread over the MHA plates with the help of a cotton swab. Then, different β-lactam antibiotic disks were placed on the spread agar surface with the help of a sterilized tweezer at the proper distance. The β-lactam antibiotics that were chosen in the present study included Methicillin (MET 10), Cephalothin (CEP 30), Ceftazidime (CAZ 30), Piperacillin/Tazobactam (PIT 100/10), Carbenicillin (CB100), Ampicillin (A25), Penicillin-G (P10), Aztreonam (AT30), Imipenem (I10), and Meropenem (MRP10). Plates were kept in the incubator at 37 °C for 24 h. Inhibition zones were measured using an antibiotic zone scale.
Antibacterial properties of isolated LAB against pathogens
Four different pathogenic bacterial strains were taken from Microbial Type Culture Collection (MTCC), namely, Staphylococcus aureus M96, Bacillus subtilis M441, Escherichia coli M730, and Klebsiella pneumoniae M109, and grown in culture tubes in nutrient broth. After inoculation, tubes were kept in a shaking incubator at 37 °C for 24 h. Along with this culture; fresh MRS broths were prepared and inoculated with isolated bacterial cultures. After the incubation period, optical density was checked for the samples and adjusted to
value 0.08-0.1 by adding fresh nutrient broth. After standardization, 100µl* of each sample was taken and spread over nutrient agar plates using a cotton swab. After spreading, 5 wells were made inside the agar plate by maintaining proper distance in between with the help of a sterile well borer. Each well was marked properly and poured with 50µl* LAB samples. Plates were kept in an incubator at 37 °C for 18-24 h. Antibacterial zones were measured using an antibiotic zone scale.
Hydrophobicity and autoaggregation activity of LAB strains
Hydrophobicity activity determination
The surface hydrophobicity properties were performed according to the method provided by Xu et al.(2009) with slight modifications [5]. Phosphate-buffered saline (PBS) was used as a control. 0.4 ml organic solvent xylene was mixed with 4 ml of bacterial suspension. After addition, the tubes were kept at room temperature for 15 min to obtain an aqueous phase. After the incubation period, the absorption values of the control and samples were taken under 600 nm wavelength. Each assay was performed in triplicate. The percentage of surface hydrophobicity was calculated using the equation below:
Surface hydrophobicity (%) =
x 100
Auto-aggregation activity determination
For auto-aggregation, the protocol given by Del Re et al. (2000) was followed with a slight modification [6]. All the bacterial cultures were grown in MRS broth overnight at 37 °C in shaking conditions. After incubation, cultures were centrifuged at 6000g for 10 min to pellet down the cells. Pellets were washed twice using PBS buffer, pH 7.4. And resuspended in PBS buffer to get a yield of
1.0. Resuspended tubes were kept at 37 °C for 2 h. After the incubation period, 0.1 ml of the upper suspension was transferred to another centrifuge tube, and the final volume was made up to 2 ml by adding 1.9 ml of PBS buffer.
values were measured for both upper suspensions diluted with PBS and total bacterial suspension by using a spectrophotometer. The percentage of autoaggregation was calculated using the equation below:
Auto aggregation (%) =
x 100
Extracellular polymeric substances (EPS) yield determination
For qualitative determination of EPS formation, bacterial samples were taken and grown in both MRS agar and broth with an additional 5% sucrose medium. After inoculation, the plates were kept in incubation at 37 °C for 48 h. After 48 h growth, non-mucoid colonies were found. They were assigned as the ropy phenotype (R) if unbreakable filaments were formed when the colonies were touched with a flame-sterilized inoculating loop. Measurements were done using a rule of the length of the filaments before breakage, and they were classified as below:
: when strand length is between 1-10 mm,
: strand length between 11-20 mm,
: 21-30.
: 31-40,
: ≥ 40 mm. In the case of the smooth, glistening, and slimy colony, they were classified as mucoid (M) if no filaments were forming [7].
For determining the yield of EPS production, the method of Joshi and Koijam, (2014) was used with minor modifications [8]. All the isolates were grown in aMRS medium containing 5% additional sucrose for 24 h at 37 °C. After incubation, 2 ml cultures were taken to different centrifuge tubes and centrifuged at 8000 g for 10 min for removing cells. 1 volume of culture supernatant was taken and added to 3 volumes of anhydrous ethanol and stored overnight at 4 °C. After 24 h of incubation, centrifugation was done, and the volume of the precipitants was adjusted to the original volume by adding an equal volume of sterilized distilled water. The total amount of EPS was determined by the presence of carbohydrates in the precipitate.
Carbohydrate determination was done by the phenol-sulfuric acid method, glucose was taken as standard. Reagents were prepared according to Tamboli et al. (2020) [9]. 100 mg glucose was taken in a test tube, and to this 5 ml 2.5 N HCl was added. The tube was kept in a hot water bath for 3 h at 100 °C. After boiling, the tubes were kept for cooling down at room temperature. To this, a sufficient amount of solid sodium carbonate (
) was added till foam formation stopped. This indicates complete neutralization. The solution was filtered, and the volume was made up to 100 ml. This was used as a standard 100 mg/ml. 0.2, 0.4, 0.6, 0.8, and 1 ml were pipetted out for making working standards in different test tubes.
Working standards volumes were made up to 1 ml by adding 0.8, 0.6, 0.4, 0.2, and 0 ml of distilled water in respective tubes. 1 ml of phenol was added to each tube. To this, 5 ml of 96%
was added to each tube and mixed well. For blank, all reagents were added except the sample solution. Tubes were left at room temperature (25-30 °C) for 15-20 min. In a hot, acidic environment, glucose dehydrates into hydroxymethyl furfural. This complex produces an orange-colored phenol product. This can be measured in a spectrophotometer at 490 nm.
Motility assay for the isolated lactic acid bacteria
The motility of the isolates was evaluated using Sulfur, Indole, and Motility (SIM) medium. The medium was prepared according to HIMEDIA® protocol, with the listed ingredients.
Overnight grown isolates were taken and inoculated using a sterile needle by stabbing inoculated into the semisolid agar tubes and kept in the incubator for 48 h at 37 °C. After the incubation period, the tubes were checked for motility. For motile bacteria, they will spread throughout the tubes, whereas non-motile bacteria will only be present throughout the stab line.
Bile salt tolerance
The ability of the bacterial isolates to grow in the presence of bile salt was determined according to the method provided by Vinderola and Reinheimer (2003) with slight modification [10]. Modified MRS broth was prepared by adding different bile salt 0.06, 0.12, 0.25, 0.5, and 1.0 % (w/v) concentrations in the medium. After inoculation, cultures were kept in an incubator at 37 °C for 24 h. After the incubation period, the optical density of each tube was measured at
and an uninoculated tube was set as blank in each case.
Acid tolerance test
The ability of the bacterial isolates to grow in the presence of an acidic medium and basic medium was determined by adjusting the pH of the MRS broth with 1N HCl and 1N NaOH. pH was adjusted to 5,7, and 8. In each case, uninoculated broth served as a control. After pH adjustment, media were sterilized and inoculated with fresh bacterial samples. After inoculation, tubes were kept in a shaker incubator at 37 °C for 24 h. After the incubation period, optical density at 600 nm was measured.
Siderophore production assay
The Chrome Azurol S (CAS) reagent was prepared as per the protocol given by Schwyn and Neilands (1987) [11]. In short, 60.5 mg of CAS reagent was dissolved in 50 ml of distilled water, and 50 ml of 1 mmol
solution was prepared in 10 mmol HCl. This solution was added to 50 ml of Cetyltrimethylammonium Ammonium Bromide (CTAB). CTAB solution was prepared by adding 91.125 mg CTAB in 50 ml distilled water. The CAS-CTAB solution was sterilized before use, and the pH was also adjusted.
Qualitative and quantitative assays were performed according to the modified method provided by Qing-Ping Hu (2011) [12]. 90 ml LB and MRS broth were taken separately, and in each conical 10 ml CAS reagent was added to prepare CAS-agar plates. Five bacterial strains were spot inoculated as well as line inoculated in each plate. After inoculation, plates were wrapped properly with parafilm and kept in an incubator at 28 °C for 72-96 h. After the incubation period, orange zone formation around the bacterial colonies was checked.
For the quantitative assay, 1 ml of 24-48 h grown fresh culture was taken in a 1.5 ml centrifuge tube and centrifuged at 10,000 x g for 10 min. After centrifugation, the pellet was discarded, and the supernatant was used for further use. 0.5 ml of each bacterial supernatant was taken in different centrifuge tubes, and 0.5 ml of CAS reagents was added to each tube. Culture supernatant and CAS reagent were mixed properly and incubated at room temperature for 20 min. After the incubation period, the optical density of each tube, including the blank, was taken at 630 nm (CECIL CE 7200, Spectrophotometer). This experiment was done in triplicate for accurate results. Siderophore produced by strains was measured in percent units (PSU), which was calculated according to the following formula [13]:
Siderophore production (PSU) = 
Where
= absorbance of reference (CAS solution and uninoculated broth), and
= absorbance of the sample (CAS solution and cell-free supernatant of the sample).
Biofilm formation assay
The study of biofilms was conducted using the methodology developed by Alshaikh et al. 2024; Coffey and Anderson 2014 with minor modifications [14, 15]. Initially, LAB isolates were grown overnight in separate MRS broths at 37 °C in shaking conditions. Next day
was measured for each sample and adjusted to 0.05 according to the McFarland standard (1.5 X
CFU/ml). After standardization, samples were diluted in a new 2 ml centrifuge tube, in a 1:100 ratio, using blank MRS broth to 100-fold dilution. From the diluted samples, 200µl* were transferred to a sterile 96-well microtiter plate. Each sample was done in triplicate to get more accurate results and for statistical analysis. A row of the plates was poured with MRS broth without any culture inoculated to set it as blank. The plate was covered with parafilm properly and placed in an incubator for a 96 h period at 37 ℃. After the incubation period, the media was carefully discarded using a 200μl pipette; while discarding the media, one should pay attention to the biofilm. After discarding the media, wells were washed with distilled water and discarded properly. After a few minutes, 125μl of 0.1% crystal violet was added to each well and waited for 10 min. Crystal violet was discarded and washed with distilled water. Then, the plate was left overnight outside at room temperature for air drying. The next day 125μl of 30% glacial acetic acid was added to each well for proper biofilm solubilization and waited for 10 min. After 10 min, optical density was measured at
nm in a microtiter plate reader. Blank was to the well in which only fresh media was added. Biofilms were observed in an inverted microscope at 50x, 100x, and 400x resolution. Images were captured for the record. The absorbance of the tested isolates was measured at
nm, and
values of<0.12 were considered biofilm negative;
values between 0.12 and 0.24 were categorized as weakly adherent and
values>0.24 were categorized as strongly adherent [16].
DNA extraction and 16S rRNA amplification of the lactic acid bacterial genome
Bacterial genomic DNA was extracted from isolated bacterial strains using the HiPurA® bacterial genomic DNA purification kit (HIMEDIA®) following the manufacturer’s protocol with fewer modifications. DNA presence was confirmed by 1.2% (w/v) agarose gel electrophoresis and visualized using Gel DocTM
System, Bio-Rad, USA. The quality of the DNA was achieved and checked using a NanoVueTm Plus Spectrophotometer (GE Healthcare Life Sciences, Sweden).
After extraction of genomic DNA, PCR amplification was done using universal primers, 27F (5′AGAGTTTGATCMTGGCTCAG3′) and 1492R (5′ACGGYTACCTTGTTACGAC TT3′) and incorporated in a 30 µl** PCR reaction mixture. The reactions were performed on a Gene Amp PCR system 9700 µ(Applied Biosystems, USA).
Sequencing data and phylogenetic tree analysis
Amplified 16S rRNA samples were sequenced at BIOLOZIK, Corporation, Assam for phylogenetic analysis. Sequencing was done by using the Sanger dideoxy sequencing method. Nucleotide sequences obtained as FASTA files were subjected to homology analysis based on 16S rRNA-targeted sequences by performing a BLAST search against a database of validly published prokaryotic-type strains [17]. The highly related sequences homologous to the query were selected and multiply aligned via the ClustalW tool in MEGA v 11.0 software. An unrooted phylogenetic tree was constructed with a neighbor-joining algorithm set at 1000 bootstrap replications to illustrate the phylogenetic relationship between the given bacterial isolates [18].
Primer designing for the determination of β-lactamase genes
It was found that PC1 is one of the most common β-lactamase genes present in Gram-positive bacteria [19]. In the National Centre for Biotechnology Information (NCBI), gene sequences were searched and chosen for primer design. Primer designing tools were used for designing the forward and reverse primers. Furthermore, primers were verified by using PCR primer statistics tools.
Gram staining and biochemical test results
It was found that all the selected isolates were Gram-positive in nature. All the isolates show similar kind of results for biochemical tests. All of the isolates showed negative results for both catalase and oxidase test.
Antimicrobial susceptibility test
The selected bacterial isolates were spread over Muller Hinton agar plates and following β-lactam antibiotic disks were placed for susceptibility testing; Methicillin (MET 10), Cephalothin (CEP 30), Ceftazidime (CAZ 30), Piperacillin/Tazobactam (PIT 100/10), Carbenicillin (CB100), Ampicillin (A25), Penicillin-G (P10), Aztreonam (AT30), Imipenem (I10), Meropenem (MRP10).
After the incubation period, in most of the cases, they showed resistance against antibiotics, and in a few cases, they showed sensitivity (table 1) according to CLSI guidelines [20].
Table 1: Antibiotics susceptibility as inhibition zone (mm) for the selected isolates from Tungtap and Lungsiej samples
| Isolate name | MET 10 | CEP 30 | CAZ 30 | PIT 100/10 | CB100 | A25 | P10 | AT30 | I10 | MRP10 |
| TT1 | R | R | R | 19.17±0.033 | R | R | R10 | R | 39.20±0.058 | 33.10±0.058 |
| TT2 | R | R | R | R | R | R | R | R | R | R |
| TT3 | 19.23±0.033 | 36.23±0.088 | R | 26.17±0.033 | R | R | R | 20.03± 0.1 | 37±0.1 | 30.13±0.167 |
| TT4 | R | R | R | R | R | R | R | R | R | R |
| TT5 | R | R | R | 23.17±0.207 | R | R | R | R | R | R |
| TT6 | 21.17±0.081 | R | R | R | 20.3±0.115 | R | R | 22.2±0.058 | 39.1±0.209 | 34.37±0.033 |
| TT7 | R | R | R | R | R | R | R | R | R | R |
| TT8 | R | R | R | R | R | R | R | R | R | R |
| TT10 | R | R | R | R | R | R | R | R | R | R |
| BS1 | R | R | R | R | R | R | R | R | 26.99±0.115 | R |
| BS2 | R | R | R | R | R | R | R | R | R | R |
| BS3 | R | R | R | R | R | R | R | R | R | 15.1±0.209 |
| BS4 | R | R | R | R | R | R | R | R | R | R |
| BS5 | R | R | R | R | R | R | R | R | R | R |
R= Resistance against the selected antibiotic; numerical values are inhibition zone in mm. These values represent the mean±SEM values of the inhibition zones found after an incubation period, n =3.
Antibacterial activity of selected lactic acid bacterial isolates
Following selected isolates TT2, TT4, TT10, BS2, and BS5 were chosen for this experiment. After incubation, no significant inhibition zone was found in all cases. This indicates selected isolates have no antibacterial activity against MTCC cultures, namely, Staphylococcus aureus M96, Bacillus subtilis M441, Escherichia coli M730, Klebsiella pneumoniae M109. Against Escherichia coli M730, four isolates showed a very small inhibition zone (fig. 1).

Fig. 1: Antibacterial activity of TT2, TT4, TT10, BS2, and BS5 isolates against Bacillus subtilis M441(a), against other pathogens (b)
Fig. 2: Co-culture studies of lactic acid bacteria isolates and Escherichia coli on modified Luria-Bertani (LB) agar plates with different salt concentrations (a), selected medium growth for pure culture isolation of Escherichia coli (b)
Co-culture of isolated lactic acid bacteria and Escherichia coli DH5α cells
Selected bacterial isolates TT2, TT4, BS2, and BS5 were chosen and grown with Escherichia coli DH5α cells at different salt concentrations (2%,4%,6%). After growing them together a loopful culture was taken and grown in Eosin Methylene Blue (EMB) agar for pure culture isolation. No metallic shinning was found in the grown isolates on EMB agar, which indicates the absence of Escherichia coli (fig. 2).
Hydrophobicity and auto-aggregation properties of the selected isolates
The cell surface hydrophobicity of these strains varied from 33.7-44.2%. TT10 exhibited higher surface hydrophobicity compared to others ~44.27%, whereas TT2, TT4, BS2, BS5 showed 35.37%, 37.725%, 33.75%, 36.64% respectively. The variation in hydrophobicity among the strains can be attributed to the diverse structural and chemical composition of bacterial surfaces, including unique hydrophobic amino acids, polysaccharides, and other cell surface components. All the selected bacterial isolates show almost similar percentages of auto-aggregation activity ~94% (fig. 3).
EPS yield determination
Qualitative yield determination
For the selected isolates, both qualitative and quantitative EPS production were measured. All the selected isolates show qualitative results between
range (
: 11-20 mm,
: 21-30 mm). TT2 showed the highest yield or highest ropiness ~23 mm, and TT10 showed the lowest ropiness properties ~10 mm. TT4, BS2, and BS5 showed 11 mm, 20 mm, and 21 mm respectively.

Fig. 3: Hydrophobicity and auto-aggregation activity of the selected five LAB isolates. Bars show the mean of independent biological replicates±SEM, n =3
Quantitative yield determination
For quantitative yield absorbance values (
) were compared with the standard glucose curve. All the isolates showed a yield of approximately 28-34μg/ml in the presence of 5% added sucrose in the medium. Without adding an extra amount of sucrose, also measure, and only 6.23 μg/ml yield was obtained. From the glucose standard curve, the following equation was obtained to determine the unknown carbohydrate concentration present in the selected isolates. Y= 0.0452X+0.027 Correlation coefficient (
= 0.9986. All the values were taken in triplicate. TT2 had the highest yield or highest concentration ~34.322μg/ml, while TT10 showed the lowest concentration ~ 28.262μg/ml. TT4, BS2, and BS5 showed 29.550μg/ml, 30.935 μg/ml, and 32.290μg/ml respectively.
Motility test
The motility of the isolates was evaluated using soft motility agar. All the tested isolates were non-motile in nature. Non-motile nature was confirmed by comparison with a positive control. Non-motile isolates were able to grow only through the stab line, while as in the case of motile bacteria; it spread all over the tube.
Bile salt tolerance of the selected isolates
The effect of five LAB isolates (TT2, TT4, TT10, BS2, BS5) exhibits diverse levels of resistance to bile salts, which is crucial for their survival and functionality as probiotics in the gastrointestinal tract. In this study, we found the selected isolates are resistant to up to 1% bile salt. All the isolates show significant growth in the presence of different bile salt percentages (w/v) (0.06%,0.12%,0.25%,0.5%, and 1.0%). BS5 shows the highest optical density at
value at 1% concentration; 0.790, while TT10 shows the lowest optical density at
; 0.185. In lower bile salt concentrations, all the isolates show similar kinds of optical density at
2.25-2.42.
Acid tolerance test
All the selected isolates were able to grow in both acidic and basic conditions. In pH 3, pH 5, and pH 8, all the isolates show notable growth. No significant difference was found in all cases.
Siderophore production and estimation of the selected isolates
For quantitative determination, the appearance of orange-colored zones around bacterial colonies in the CAS agar plates indicates siderophore production by the selected LAB isolates. In this study, all bacterial strains tested positive for the siderophore production. Among them, TT10 exhibited the highest siderophore production. The siderophore production was roughly estimated based on the size of the halos formed on CAS agar plates. However, the CAS agar method provides only a rough estimate and is not ideal for precise quantification. Therefore, quantitative estimation of siderophore production was performed using liquid culture media and the CAS reagent.
Quantitative determination of siderophore production of the selected isolates was obtained by measuring their optical density value at
OD value was measured in two different intervals, one after 24 h incubation and another after 48 h of incubation. Among all the isolates, TT10 showed the highest siderophore production in both cases after 24h and 48 h. After 24 h the percentage of siderophore production was 15.8±0.3000, 31.86±0.0949, 35.36±0.1, 17.86±0.03, and 16.89±0.08 PSU for TT2, TT4, TT10, BS2, and BS5 respectively. After 48 h the results were 24.56±0.2912, 35.68±0.3095, 38.477±0.2, 21.34±0.2, and 17.88±0.1PSU respectively. In each case, siderophore production was found higher in 48 h than in 24 h.
Biofilm formation capacity
A qualitative assay for the biofilm formation was done using microscopic visualization after staining with crystal violet. The optical density of the selected isolates was measured at 490 nm and found to be 0.142±0.0018, 0.115±0.0011, 0.118±0.0012, 0.458±0.0015, and 0.24±0.0016 for TT2, TT4, TT10, BS2, and BS5, respectively. From the compared value, it was found two isolates (TT4, TT10) can be considered biofilm negative, one isolate was weakly adherent (TT2), and the other two isolates (BS2, BS5) were found strongly adherent (fig. 4).

Fig. 4: Biofilm formation qualitative assay; 1a,1b,1c represent microscopic visualization of the biofilm, 2a represent positive control, 2b represents a sample, 2c represents negative control 96-well titer plate images, B4 represents the biofilm formation after incubation period without any treatment, 3 represent the optical density of the selected isolates at 490 nm for measuring biofilm formation (a-e show significant differences between each other). Bars show the mean of independent biological replicates±SEM, n =3. Statistical significance was determined using a one-way ANOVA test. A significant difference was found among means (P<0.05)
Genomic DNA and 16S rRNA isolation of the selected LAB isolates
This study evaluated DNA extraction of different lactic acid bacteria isolated from locally available fermented food; tungtap and lung-siej. After DNA extraction using HiPurA® bacterial genomic DNA purification kit (HIMEDIA®), eluted DNA was run in agarose gel electrophoresis and visualized in imaging software (Gel Doc™ XR+system, Bio-Rad, USA).
From the extracted genomic DNA, 16S rRNA of the selected isolates was isolated by using a thermal cycler; after isolation, samples were run in 1.2% agarose gel electrophoresis and then visualized by using Bio-Rad imaging software. A known 1kb marker was used for the comparison study, as 16S rRNA sizes are generally around 1600 bp in size. The amplicons appear between 1000-2000 bp, which suggests appropriate size separation for the gene (fig. 5).

Fig. 5: (a) Genomic DNA visualization in Bio-Rad imaging software, (b) PCR amplified product of the 16S rRNA of the isolates from tungtap and lung-siej samples
Sequencing data analysis and phylogenetic tree analysis
Sequencing was done from BIOLOZIK Corporation, Guwahati, Assam. The isolates were subjected to a nucleotide BLAST similarity search processed against related bacterial lineage sequences in the EZBiocloud database (https://www.ezbiocloud.net/resources). Phylogenetic analysis based on 16S rRNA sequences helped in confirming the identity of the isolates up to their species level. The analysis confirmed the sequence identification, showing 97-99% sequence similarity to their nearest match homologs. The highly related sequences homologous to the query were selected and multiply aligned via the ClustalW tool in MEGA v 11.0 software (fig. 6). Majorly, Lactiplantibacillus sp. was found in both tungtap and lung-siej samples while Ligilactibacillus sp. was found in tungtap samples.
The gene sequences were deposited in the NCBI Gene Bank database, and accession numbers were obtained. The sequence length and gene identity percentage were recorded and tabulated (table 2).
PCR amplification of selected β-lactam resistance genes
Polymerase chain reaction was done with the designed primers; same protocol was followed here, which was previously followed for 16S rRNA isolation. A clear band was found above 1000bp, around the 1053 base pair (fig. 7), which suggests the presence of PC1 β-lactamase in the tungtap isolates. This suggests the presence of the gene, but further purification and sequencing are required for confirmation.

Fig. 6: A phylogenetic tree of bacterial isolates from tungtap and lung-siej samples with their nearest homologs based on 16S rRNA sequence similarity
Table 2: Molecular identification of bacterial isolates from tungtap and lung-siej samples
| S. No. | Isolates | Identified as | Accession No. | Length (bp) | %Gene identity |
| 1 | RGhTT2 | Lactiplantibacillus pentosus | PQ008573 | 1470 | 97.61 |
| 2 | RGhTT3 | Ligilactobacillus pobuzihii | PQ008574 | 1374 | 99.78 |
| 3 | RGhTT4 | Lactiplantibacillus pingfangensis | PQ008575 | 1478 | 98.67 |
| 4 | RGhTT7 | Ligilactobacillus acidipiscis | PQ008576 | 1212 | 99.01 |
| 5 | RGhTT10 | Lactiplantibacillus argentoratensis | PQ008577 | 1345 | 99.93 |
| 6 | RGhBS2 | Lactiplantibacillus pentosus | PQ008578 | 1356 | 100 |
| 7 | RGhBS5 | Lactiplantibacillus pingfangensis | PQ008579 | 1475 | 98.66 |

Fig. 7: PCR amplified product of PC1 β-lactamase gene [amplicon size ~ 1053bp]
The present study aimed to isolate and characterize LAB isolates from locally available fermented products; fermented fish (Tung tap) and fermented bamboo shoots (Lung-seij), assessing their probiotic properties and various functional properties, and antibiotic resistance properties specifically against β-lactam antibiotics. The findings from this comprehensive analysis provide valuable insights into the probiotic capabilities and genetic characteristics of these LAB isolates.
A total of sixteen LAB isolates were chosen from the locally available tung tap and lung-siej samples based on their morphological, biochemical characterization, and antimicrobial susceptivity assay results. All the isolates show similar kinds of biochemical test results. Based on these characteristics, a total of five isolates were chosen, three from Tung tap (TT2, TT4, TT10) and two from lung-siej (BS2, BS5) samples.
The antimicrobial susceptibility test revealed that all the selected LAB isolates were resistant to most of the tested β-lactam antibiotics according to CLSI guidelines. Mostly LAB is recognized as GRAS or Qualified Presumption of Safety (QPS); however, there is a possibility that these strains could become reservoirs for antimicrobial resistance genes [21, 22].
The ability to survive in the gastrointestinal tract condition is one of the most important features to consider when selecting a probiotic [23]. In this study, the pH of 6.6, 3.0, and 8.0 correspond to the oral cavity, stomach, and large intestine, respectively, and bile salt in the small intestine was evaluated (0.3% and 0.6% (w/v)) [24]. Moreover, they were even tolerant to 1.0% of bile salt too. All five strains were tolerant to all the tested pH levels and bile salt. The different methods each strain employs to tolerate pH and bile salts are unique to each strain and may be the reason for their survival in the gastrointestinal system. For instance, Lactobacillus sp. employs different mechanisms like proton pump, membrane lipid content modification, biofilm formation, and aiding in auto-aggregation to survive in different extreme conditions [25, 26].
Auto aggregation is a desired characteristic for probiotics as it ensures that they reach the intestine in high numbers, protecting them from stress conditions. This property enables probiotics to interact with the host, adhere to and colonize the Gastrointestinal Tract (GIT), and exert beneficial effects, such as inhibiting the growth of potential pathogens [27]. According to Cisneros et al. (2021), auto-aggregation percentages equal to or lower than 10% indicate that the strain is unable to auto-aggregate [28]. In contrast, strains with a percentage higher than 10% can naturally auto-aggregate. In this study, all five isolates exhibit around 94% auto-aggregation values.
Hydrophobicity in probiotics is related to the interaction between the bacterial surface and intestinal epithelial cells. This property is dependent on non-polar molecules in the membranes and cell walls, such as glycoproteins and polysaccharides [29]. Hydrophobicity is an indirect estimate of successful adhesion and colonization, allowing characterization of the surface’s ability to interact with the mucosa and intestinal cells, but it's not a prerequisite for string adhesion [30]. In this study, it was found all the strains showed hydrophobicity varied from 33.7% to 44.2%, where TT10 showed the highest among them.
Visual screening of colonies on a solid culture medium is a common method for detecting EPS production. EPS production is dependent on carbon and nitrogen sources, with additional sucrose in the media promoting growth in screening EPS-producing colonies [31]. In this study, TT2 was the highest EPS producer in phenotypic measurement of ropiness formed. In the quantitative study, the selected isolates showed 28-34 µg/ml EPS yield through phenol-chloroform assay.
Siderophore production is another vital trait for probiotics, which play a significant role in their survival and competitive advantages in various environments, including the human gut. In the case of probiotic strains, siderophore production enhances their ability to compete with pathogenic strains for iron, thereby inhibiting the growth of these harmful microorganisms. In this study, we found that the highest siderophore producer was approximately 38.4 PSU. Alshaikh et al. (2024) found in their study that 65% of isolates that displayed iron chelation using the CAS assay and those siderophore-producing isolates were significantly more resistant to β-lactam antibiotics, chloramphenicol, and ciprofloxacin [14].
Understanding the relationship between biofilm formation and antibiotic resistance is critical for developing preventive measures for biofilm-associated infections. Numerous studies found inconsistent results regarding the relationship between biofilm formation and antimicrobial resistance [32]. In this also a significant negative correlation was detected between antibiotic resistance and biofilm formation. TT4 and TT10 demonstrated high resistance to tested antibiotics, but biofilm formation showed negative results. TT2 formed a weak biofilm but showed high resistance properties against tested β-lactam antibiotics.
Sequencing and phylogenetic studies reveal that most of the lactic acid bacterial strains are from the genus Lactiplntibacillus, and some are from Ligilactibacillus sp. Lactiplntibacillus is widely used in the food industry for its functional properties, like improving the nutritional and sensory quality of fermented foods, maintaining eubiotics of the host’s gut microbiome, etc. [33]. Ligilactibacillus sp. are mainly found in vertebrate hosts. Some species are also present in fermented foods and are industrially exploited as starters or probiotics. Ligilactobacillus acidipiscisis commonly found in fermented fish [34].
The polymerase chain reaction of the designed β-lactamase genes (blaTEM, PC1) gives us a rough idea regarding their presence in the isolated strains, as the gel electrophoresis images show a light band for the selected genes.
In this study, we found that the isolated strains from fermented fish and bamboo shoot samples showed potential probiotic properties. All the isolates were able to grow under different stress conditions like temperature (25-45 °C), pH (3.0-8.0), and salt concentration (up to 8% v/w). This indicates the isolates are good probiotics and opens up the possibility of using them as starter cultures. The bacterial isolates described in the present study were resistant to all of the selected β-lactam antibiotics. Interestingly, the isolates did not show any antimicrobial activity against the selected pathogenic strains. Though there is a relation between biofilm formation and antibiotic resistance, in the present study, a mixed observation was made with some isolates having prominent biofilm formation as well as non-biofilm-forming isolates that also showed resistance against the selected β-lactam antibiotics. Further study is required to establish whether the isolates are transmitting their antimicrobial resistance genes during co-culture under different stress conditions and transportation.
The authors of this research did not receive any funding concerning this research.
The work was designed by SRJ and AKR. RG carried out the experimental work, generated the data, wrote and revised the MS. SRJ and RG analyzed the data.
The authors have no conflict of interest.
Pohsnem JM, Ramakrishnan E, Parasar DP. Fermented food products in the Himalayan belt (North East India) and their health benefits. Int J Gastronomy Food Sci. 2023 Mar;31:100676. doi: 10.1016/j.ijgfs.2023.100676.
Vinayamohan PG, Viju LS, Joseph D, Venkitanarayanan K. Fermented Foods as a Potential vehicle of antimicrobial-resistant bacteria and genes. Fermentation. 2023 Jul 22;9(7):688. doi: 10.3390/fermentation9070688.
Wang Y, Wu J, Lv M, Shao Z, Hungwe M, Wang J. Metabolism characteristics of lactic acid bacteria and the expanding applications in food industry. Front Bioeng Biotechnol. 2021 May;9:612285. doi: 10.3389/fbioe.2021.612285, PMID 34055755.
Leech J, Cabrera Rubio R, Walsh AM, Macori G, Walsh CJ, Barton W. Fermented-food metagenomics reveals substrate-associated differences in taxonomy and health-associated and antibiotic resistance determinants. mSystems. 2020 Dec 22;5(6):e00522-20. doi: 10.1128/mSystems.00522-20, PMID 33172966.
Xu H, Jeong HS, Lee HY, Ahn J. Assessment of cell surface properties and adhesion potential of selected probiotic strains. Lett Appl Microbiol. 2009 Oct;49(4):434-42. doi: 10.1111/j.1472-765X.2009.02684.x, PMID 19725886.
Del Re B, Sgorbati B, Miglioli M, Palenzona D. Adhesion, autoaggregation and hydrophobicity of 13 strains of Bifidobacterium longum. Lett Appl Microbiol. 2000 Dec;31(6):438-42. doi: 10.1046/j.1365-2672.2000.00845.
Ramos IM, Sesena S, Poveda JM, Palop ML. Screening of lactic acid bacteria strains to improve the properties of non-fat set yogurt by in situ EPS production. Food Bioprocess Technol. 2023 Nov;16(11):2541-58. doi: 10.1007/s11947-023-03080-7.
Joshi SR, Koijam K. Exopolysaccharide production by a lactic acid bacteria, leuconostoc lactis isolated from ethnically fermented beverage. Natl Acad Sci Lett. 2014 Feb;37(1):59-64. doi: 10.1007/s40009-013-0203-6.
Tamboli FA, More HN, Bhandugare SS, Patil AS, Jadhav NR, Killedar SG. Estimation of Total carbohydrate content by phenol sulphuric acid method from Eichhornia crassipes (Mart.) solms. Asian J Res Chem. 2020;13(5):357-9. doi: 10.5958/0974-4150.2020.00067.
Vinderola CG, Reinheimer JA. Lactic acid starter and probiotic bacteria: a comparative “in vitro” study of probiotic characteristics and biological barrier resistance. Food Res Int. 2003 Jan;36(9-10):895-904. doi: 10.1016/S0963-9969(03)00098-X.
Schwyn B, Neilands JB. Universal chemical assay for the detection and determination of siderophores. Anal Biochem. 1987 Jan;160(1):47-56. doi: 10.1016/0003-2697(87)90612-9, PMID 2952030.
Hu QP. A simple double-layered chrome azurol sagar (SD-CASA) plate assay to optimize the production of siderophores by a potential biocontrol agent Bacillus. Afr J Microbiol Res. 2011 Nov 9;5(25). doi: 10.5897/AJMR11.238.
Leon Sicairos N, Angulo Zamudio UA, de la Garza M, Velazquez Roman J, Flores Villasenor HM, Canizalez Roman A. Strategies of Vibrio parahaemolyticus to acquire nutritional iron during host colonization. Front Microbiol. 2015 Jul 9;6:702. doi: 10.3389/fmicb.2015.00702, PMID 26217331, PMCID PMC4496571.
Alshaikh SA, El-banna T, Sonbol F, Farghali MH. Correlation between antimicrobial resistance, biofilm formation, and virulence determinants in uropathogenic Escherichia coli from Egyptian hospital. Ann Clin Microbiol Antimicrob. 2024 Feb 24;23(1):20. doi: 10.1186/s12941-024-00679-2, PMID 38402146.
Coffey BM, Anderson GG. Biofilm formation in the 96-well microtiter plate. In: Filloux A, Ramos JL, editors. Pseudomonas methods and protocols. New York: Springer; 2014 Jun 26. p. 631-41. doi: 10.1007/978-1-4939-0473-0_48, PMID 24818938.
Fredheim EG, Klingenberg C, Rohde H, Frankenberger S, Gaustad P, Flaegstad T. Biofilm formation by Staphylococcus haemolyticus. J Clin Microbiol. 2009 Apr;47(4):1172-80. doi: 10.1128/JCM.01891-08, PMID 19144798.
Chalita M, Kim YO, Park S, Oh HS, Cho JH, Moon J. EzBioCloud: a genome-driven database and platform for microbiome identification and discovery. Int J Syst Evol Microbiol. 2024 Jul 11;74(6). doi: 10.1099/ijsem.0.006421, PMID 38888585.
Tamura K, Stecher G, MEGA KS. Molecular evolutionary genetics analysis. Version 11 Battistuzzi FU, editor. Mol Biol Evol. 2021 Jun 25;38(7):3022-7. doi: 10.1093/molbev/msab120.
Rokon-Uz-Zaman M, Bushra A, Pospo TA, Runa MA, Tasnuva S, Parvin MS. Detection of antimicrobial resistance genes in lactobacillus spp. from poultry probiotic products and their horizontal transfer among Escherichia coli. Vet Anim Sci. 2023;20:100292. doi: 10.1016/j.vas.2023.100292, PMID 36942055.
Cockerill FR. Clinical and Laboratory Standards Institute, editors. Performance standards for antimicrobial susceptibility tests: approved standard-eleventh edition. Wayne PA. CLSI. Clinical and Laboratory Standards Institute; 2012. p. 58.
Nascimento LC, Casarotti SN, Todorov SD, Penna AL. Probiotic potential and safety of enterococci strains. Ann Microbiol. 2019;69(3):241-52. doi: 10.1007/s13213-018-1412-5.
Nascimento LC, Casarotti SN, Todorov SD, Penna AL. Probiotic potential and safety of enterococci strains. Ann Microbiol. 2019 Mar;69(3):241-52. doi: 10.1007/s13213-018-1412-5.
Stefanska I, Kwiecieb E, Jozwiak Piasecka K, Garbowska M, Binek M, Rzewuska M. Antimicrobial susceptibility of lactic acid bacteria strains of potential use as feed additives–the basic safety and usefulness criterion. Front Vet Sci. 2021 Jul 1;8:687071. doi: 10.3389/fvets.2021.687071, PMID 34277757.
Fernandes ML, Perin LM, Todorov SD, Nero LA, Alencar ER, Ferreira MD. In vitro evaluation of the safety and probiotic and technological potential of Pediococcus pentosaceus isolated from sheep milk. SCA. 2018 Feb 16;39(1):113. doi: 10.5433/1679-0359.2018v39n1p113.
Hu PL, Yuan YH, Yue TL, Guo CF. Bile acid patterns in commercially available oxgall powders used for the evaluation of the bile tolerance ability of potential probiotics. PLOS ONE. 2018 Mar 1;13(3):e0192964. doi: 10.1371/journal.pone.0192964, PMID 29494656.
Wang YC, Huang TW, Yang YS, Kuo SC, Chen CT, Liu CP. Biofilm formation is not associated with worse outcome in acinetobacter baumannii bacteraemic pneumonia. Sci Rep. 2018 May 8;8(1):7289. doi: 10.1038/s41598-018-25661-9, PMID 29740176.
Guan N, Liu L. Microbial response to acid stress: mechanisms and applications. Appl Microbiol Biotechnol. 2020 Jan;104(1):51-65. doi: 10.1007/s00253-019-10226-1, PMID 31773206.
Trunk T, Khalil HS, Leo JC. Bacterial autoaggregation. AIMS Microbiol. 2018;4(1):140-64. doi: 10.3934/microbiol.2018.1.140, PMID 31294207.
Cisneros L, Cattelan N, Villalba MI, Rodriguez C, Serra DO, Yantorno O. Lactic acid bacteria biofilms and their ability to mitigate Escherichia coli O157:H7 surface colonization. Lett Appl Microbiol. 2021 Aug;73(2):247-56. doi: 10.1111/lam.13509, PMID 34008189.
Roldan Perez S, Gomez Rodriguez SL, Sepulveda Valencia JU, Ruiz Villadiego OS, Márquez Fernandez ME, Montoya Campuzano OI. Assessment of probiotic properties of lactic acid bacteria isolated from an artisanal Colombian cheese. Heliyon. 2023 Nov;9(11):e21558. doi: 10.1016/j.heliyon.2023.e21558, PMID 38027952.
Luan C, Jiang N, Zhou X, Zhang C, Zhao Y, Li Z. Antibacterial and anti-biofilm activities of probiotic Lactobacillus curvatus BSF206 and Pediococcus pentosaceus AC1-2 against Streptococcus mutans. Microb Pathog. 2022 Mar;164:105446. doi: 10.1016/j.micpath.2022.105446, PMID 35167954.
Milanovic V, Osimani A, Garofalo C, Belleggia L, Maoloni A, Cardinali F. Selection of cereal-sourced lactic acid bacteria as candidate starters for the baking industry. PLOS ONE. 2020 Jul 23;15(7):e0236190. doi: 10.1371/journal.pone.0236190, PMID 32702068.
Eyoh AB, Toukam M, Atashili J, Fokunang C, Gonsu H, Lyonga EE. Relationship between multiple drug resistance and biofilm formation in Staphylococcus aureus isolated from medical and non-medical personnel in Yaounde, Cameroon. Pan Afr Med J. 2014;17:186. doi: 10.11604/pamj.2014.17.186.2363, PMID 25396012.
Echegaray N, Yilmaz B, Sharma H, Kumar M, Pateiro M, Ozogul F. A novel approach to Lactiplantibacillus plantarum: from probiotic properties to the omics insights. Microbiol Res. 2023 Mar;268:127289. doi: 10.1016/j.micres.2022.127289, PMID 36571922.
Tohno M, Tanizawa Y, Sawada H, Sakamoto M, Ohkuma M, Kobayashi H. A novel species of lactic acid bacteria, Ligilactobacillus pabuli sp. nov., isolated from alfalfa silage. Int J Syst Evol Microbiol. 2022 Oct 21;72(10). doi: 10.1099/ijsem.0.005587, PMID 36269574.